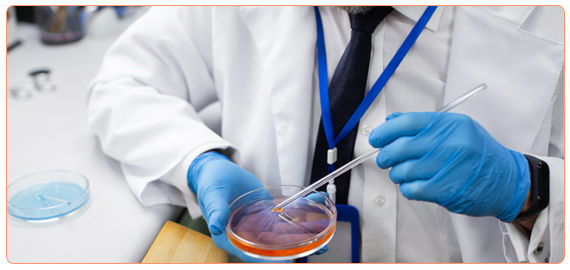

Surrogacy law in the United States is complex and varies significantly by state. Some states embrace surrogacy with clear statutes and protections, while others impose restrictions or prohibit certain arrangements. For intended parents, navigating these differences is essential to avoid delays, unexpected costs, or even legal disputes.
At Surrogacy4All, we combine physician-led medical care with trusted surrogacy attorneys to ensure a safe, transparent, and ethical journey for both parents and surrogates.
The lab is where fertilization occurs, embryos are cultured, and decisions about embryo transfer are made. Embryologists use advanced incubators, microscopes, and monitoring systems to ensure optimal embryo growth. They also perform techniques like ICSI (injecting sperm into an egg) and assisted hatching.
Research shows that blastocyst transfer often improves outcomes, but not all patients reach this stage. Lab quality plays a large role in whether embryos survive to Day 5.
Embryos are graded based on cell number, symmetry, and fragmentation on Day 3, and inner cell mass/trophectoderm quality on Day 5. Grades are predictive, but not guarantees. Many ‘average’ embryos still lead to healthy babies.
Embryologists handle the most delicate materials in medicine: gametes and embryos. Their skill in ICSI, biopsy for genetic testing, and cryopreservation is critical to success. Patients often never meet their embryologist, but their work is central to creating life.
Lab conditions (air quality, pH, temperature, light exposure) all influence embryo health. Even small lapses in quality control can affect implantation and pregnancy outcomes. Clinics with rigorous lab standards consistently achieve higher success rates.
Lab procedures add to IVF costs:

Maria and David had undergone two IVF cycles at a large clinic with poor success. They had embryos reach Day 3 but none progressed to Day 5. Their doctor suggested they might need donor eggs.
Seeking a second opinion, they came to Surrogacy4All. Our physicians recommended a clinic with state-of-the-art lab technology. In their very next cycle, 8 eggs were retrieved, 6 fertilized, and 3 developed into healthy blastocysts by Day 5. One embryo was transferred, and Maria became pregnant.
Maria recalls: ‘We didn’t realize how much lab quality mattered. Switching labs changed everything for us.’
‘Our embryologist explained every detail of our embryos. That transparency gave us so much peace of mind.’
Intended Parents
‘We thought all clinics had the same labs, but Surrogacy4All showed us how to choose wisely.’
IVF Patient
Embryology and lab science are the backbone of IVF success. Choosing a clinic with advanced lab facilities can double your chances of success. At Surrogacy4All, we partner only with clinics that maintain world-class embryology labs.
📞 Call (212) 661-7177 to schedule a consultation and learn how lab science impacts your journey.
Our job is to listen, to connect the dots between your needs, and to determine how we can best help you have your baby. If you’re asking how much does it cost for a surrogate, we’ll walk you through every step of the process to ensure there are no surprises.
To make an appointment with one of our counselors or physicians, please call (212) 661-7673 or email info@surrogacy4all.com. We look forward to hearing from you.
Secret Guide to Minimizing Surrogacy Costs
All Rights Reserved to Surrogacy4all
RESOLVE: The National Infertility Association, established in 1974, is dedicated to ensuring that all people challenged in their family building journey reach resolution through being empowered by knowledge, supported by community, united by advocacy, and inspired to act.
ASRM is a multidisciplinary organization dedicated to the advancement of the science and practice of reproductive medicine. The Society accomplishes its mission through the pursuit of excellence in education and research and through advocacy on behalf of patients, physicians, and affiliated health care providers.
Welcome to the Parent Guide: Starting Life Together, for children and their caregivers. Whether you are a mother or father (through birth, adoption, or foster care), a grandparent, partner, family friend, aunt or uncle with parenting responsibilities, the Parent Guide has information to help you through the FIRST FIVE YEARS of your parenting journey.
Path2Parenthood (P2P) is an inclusive organization committed to helping people create their families of choice by providing leading-edge outreach programs.
The FDA is a part of the Department of Health and Human Services.
Each day in America, you can trust the foods you eat and the medicines you take, thanks to the U.S. Food and Drug Administration.